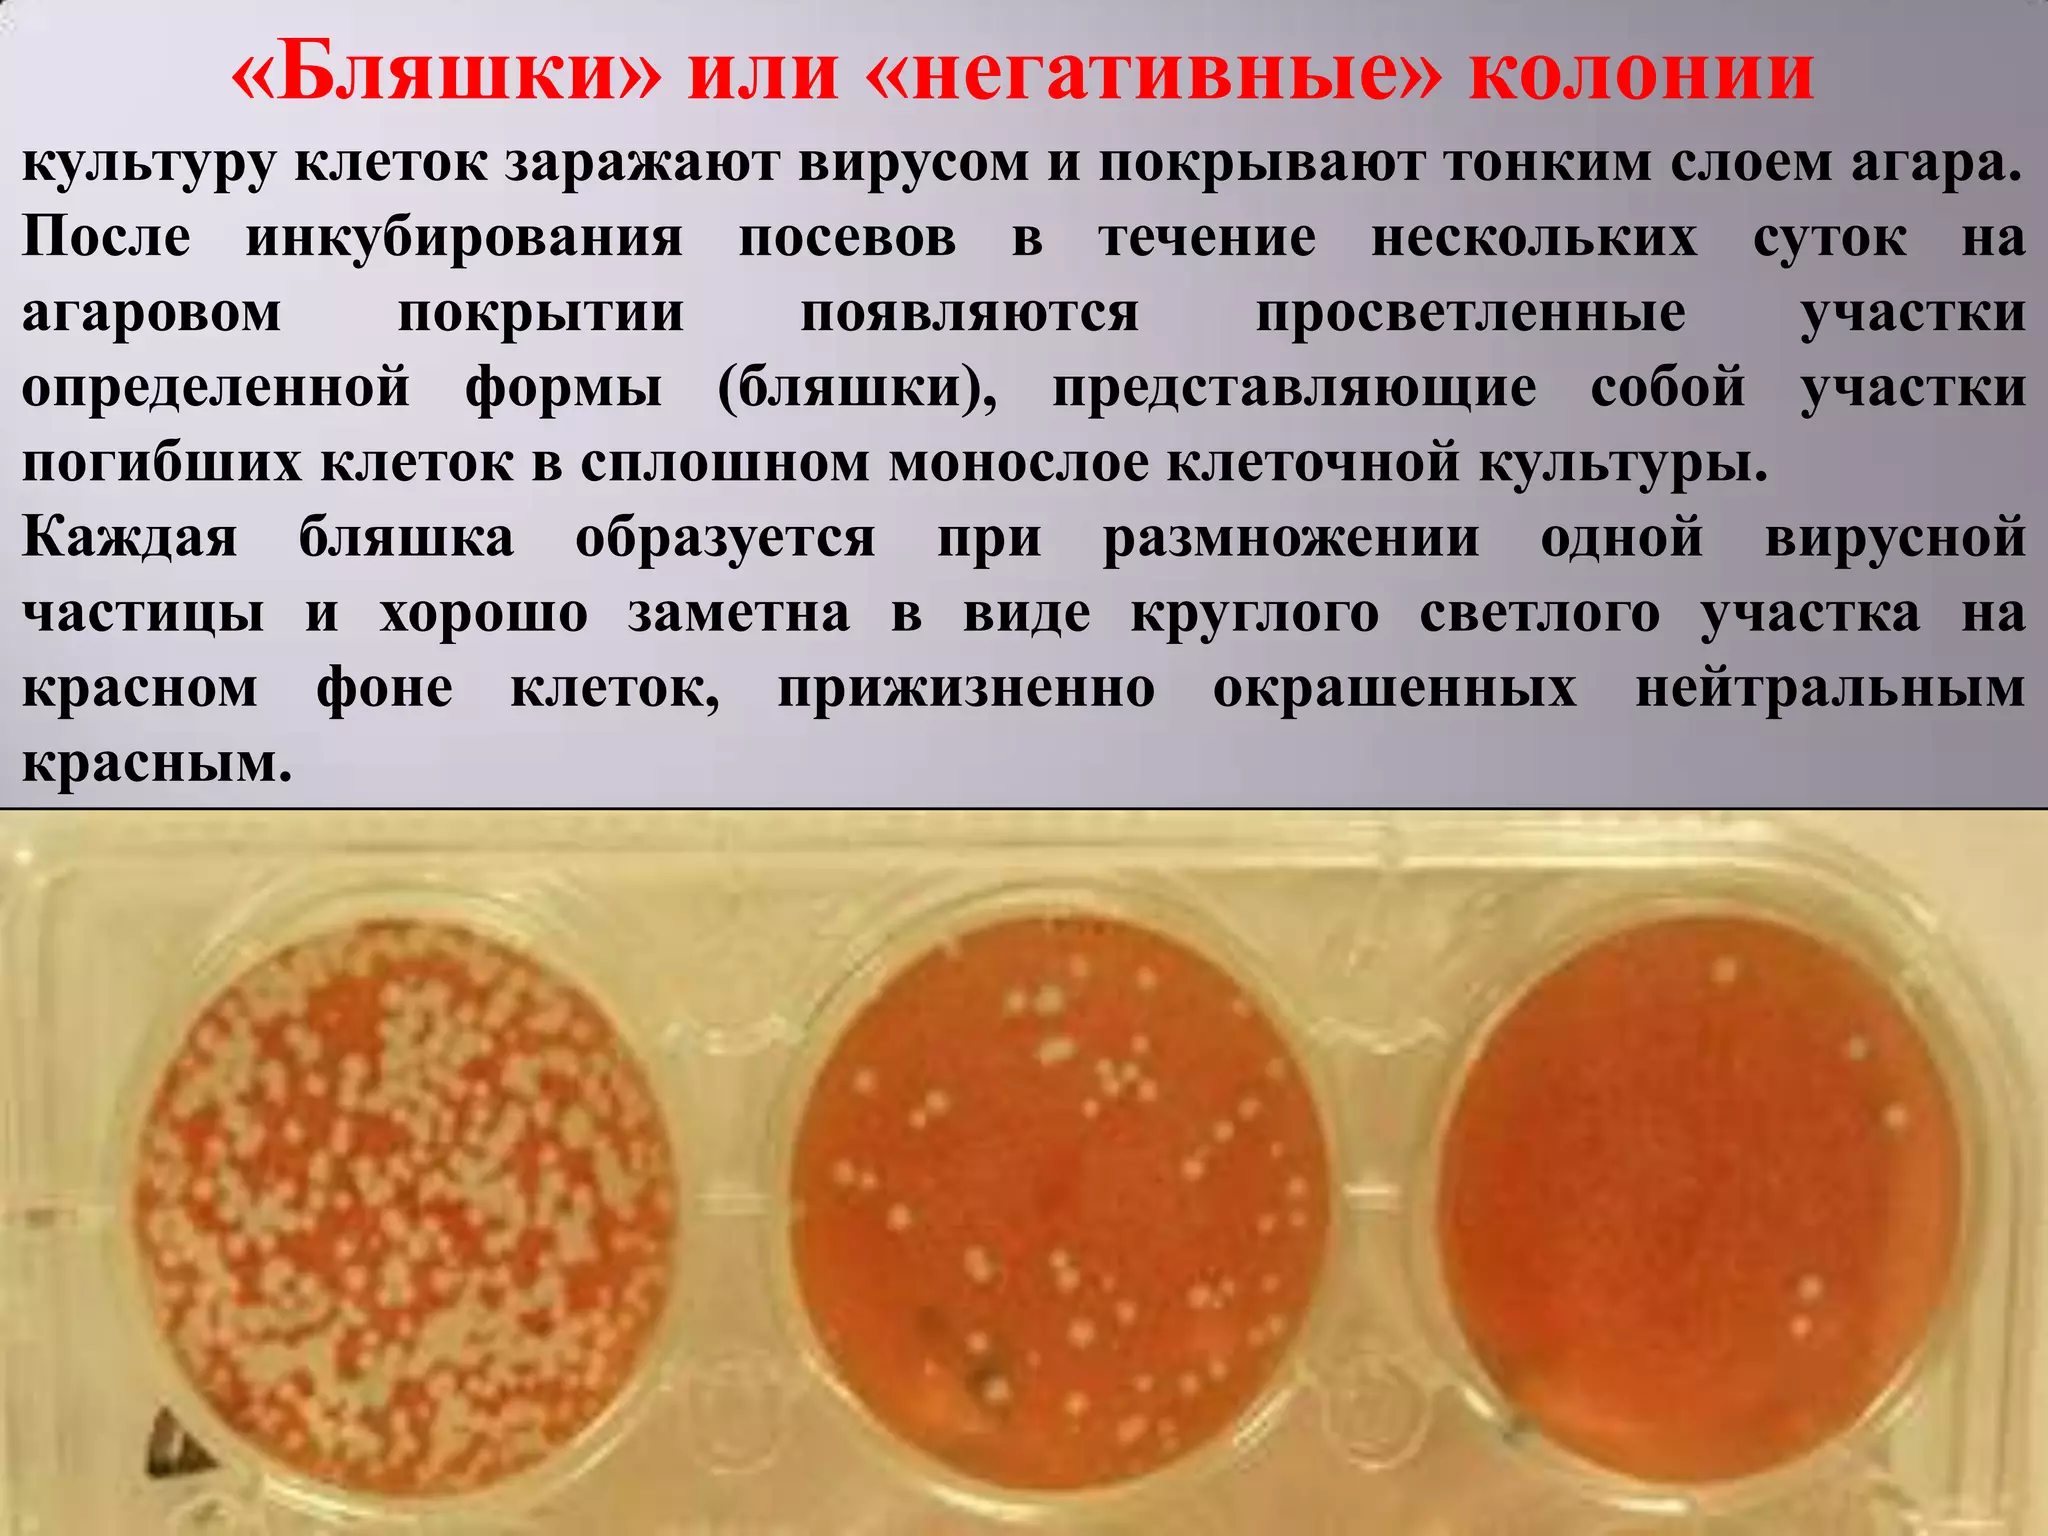
«Бляшки» или «негативные» колонии
культуру клеток заражают вирусом и покрывают тонким слоем агара.
После инкубирования посевов в течение нескольких суток на
агаровом    покрытии     появляются    просветленные    участки
определенной формы (бляшки), представляющие собой участки
погибших клеток в сплошном монослое клеточной культуры.
Каждая бляшка образуется при размножении одной вирусной
частицы и хорошо заметна в виде круглого светлого участка на
красном фоне клеток, прижизненно окрашенных нейтральным
красным.

Документ описывает вирусы, их структуру, жизненный цикл и методы их обнаружения и идентификации. Вирусы представлены как облигатные внутриклеточные паразиты с одним типом нуклеиновой кислоты, которые размножаются путем дизъюнктивного типа. Основные методы диагностики включают вирусологические, серологические и молекулярные подходы, такие как ПЦР.